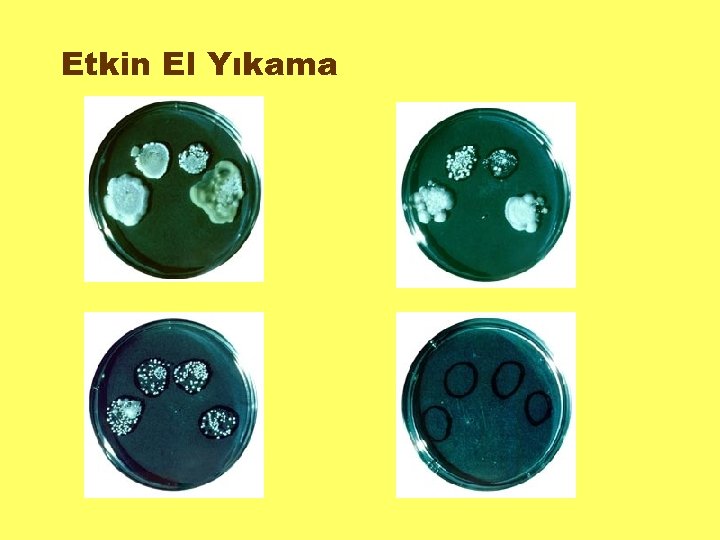

50b3ceea9c4175847741ec55a64884ec.ppt
- Количество слайдов: 50
 GIDA İŞLETMELERİNDE HİJYEN ve SANİTASYON Prof. Dr. Kadir HALKMAN Ankara Üniversitesi Mühendislik Fakültesi Gıda Mühendisliği Bölümü 22 Şubat 2006, Antalya
GIDA İŞLETMELERİNDE HİJYEN ve SANİTASYON Prof. Dr. Kadir HALKMAN Ankara Üniversitesi Mühendislik Fakültesi Gıda Mühendisliği Bölümü 22 Şubat 2006, Antalya
 "Gıda İşletmesi" Gıdanın üretildiği ve/veya tüketiciye sunulduğu her yerdir. Tüm gıda işletmelerinde temel hijyen ve sanitasyon kurallarına mutlaka uyulması gerekir.
"Gıda İşletmesi" Gıdanın üretildiği ve/veya tüketiciye sunulduğu her yerdir. Tüm gıda işletmelerinde temel hijyen ve sanitasyon kurallarına mutlaka uyulması gerekir.
 Hijyen: Sağlıklı ortamın korunması, iyileştirilmesi, her türlü hastalık etmeninden arındırılması için gerekli prensipleri içeren bir sistemdir. M. Ö. 2000 yılında el hijyeni ile gündeme gelmiştir. Sanitasyon: Çevreyi temiz ve sağlıklı tutarak insan sağlığının korunmasına yardımcı olan ve dolayısıyla hijyenin hizmetinde, hijyenin bir öğesi olarak kabul edilen bir kavramdır. Temizlik: bir madde ya da cismin estetik açıdan görümünü bozan, görünen ya da görünmeyen her türlü kirin ortamdan uzaklaştırılmasıdır. Dezenfeksiyon: Yüzeylerin her türlü hastalık yapıcı etkenlerden yani mikroorganizmalardan arındırılması (öldürmek veya güvenilir seviyelere indirmek) için uygulanan kimyasal işlemlerdir.
Hijyen: Sağlıklı ortamın korunması, iyileştirilmesi, her türlü hastalık etmeninden arındırılması için gerekli prensipleri içeren bir sistemdir. M. Ö. 2000 yılında el hijyeni ile gündeme gelmiştir. Sanitasyon: Çevreyi temiz ve sağlıklı tutarak insan sağlığının korunmasına yardımcı olan ve dolayısıyla hijyenin hizmetinde, hijyenin bir öğesi olarak kabul edilen bir kavramdır. Temizlik: bir madde ya da cismin estetik açıdan görümünü bozan, görünen ya da görünmeyen her türlü kirin ortamdan uzaklaştırılmasıdır. Dezenfeksiyon: Yüzeylerin her türlü hastalık yapıcı etkenlerden yani mikroorganizmalardan arındırılması (öldürmek veya güvenilir seviyelere indirmek) için uygulanan kimyasal işlemlerdir.
 Hijyen Kurallarını Oluşturan Öğeler: Genel Hijyen Beklentileri: Temizlik, Dezenfeksiyon, Hijyen (GHP), Zararlılarla Mücadele, Çöp ile Mücadele. İşletme içi Önlemler ve Kontroller: HACCP, GMP, Sistemi Kontrol Altında Tutmak. Kodeks, İşletme Standartları, Diğer Standartlar.
Hijyen Kurallarını Oluşturan Öğeler: Genel Hijyen Beklentileri: Temizlik, Dezenfeksiyon, Hijyen (GHP), Zararlılarla Mücadele, Çöp ile Mücadele. İşletme içi Önlemler ve Kontroller: HACCP, GMP, Sistemi Kontrol Altında Tutmak. Kodeks, İşletme Standartları, Diğer Standartlar.
 En Etkili Hijyen Kuralı: Örnek Davranıştır Hijyen Dostları • Anlaşılır Bilgi Akışı • Samimi Açıklamalar • İlgiliye Haber Vermek • Basit Afişler • İlan Tahtası • Taktir / Övgü Hijyen Düşmanları • Vakit Azlığı • Günlük Yoğun İşler • Tedarikte Boşluk • Eksik Bilgi • Rahatlık • İletişim Yetersizliği
En Etkili Hijyen Kuralı: Örnek Davranıştır Hijyen Dostları • Anlaşılır Bilgi Akışı • Samimi Açıklamalar • İlgiliye Haber Vermek • Basit Afişler • İlan Tahtası • Taktir / Övgü Hijyen Düşmanları • Vakit Azlığı • Günlük Yoğun İşler • Tedarikte Boşluk • Eksik Bilgi • Rahatlık • İletişim Yetersizliği
 Mikroorganizmalar = Mikroplar - Bakteriler, Mayalar, Küfler, Algler, Protozoa gözle görülmez; çok küçüktür. - Virüsler ayrı bir gruptur, çok küçüktür. - Şapkalı Mantarlar, Yosunlar, Likenler gözle görülebilir. - Koloni gözle görülebilir. Koloni milyarlarca mikroorganizmanın yaptığı özel bir topluluktur. Ekmek ve limondaki küf, reçeldeki maya, sirke anası, iltihaplı sivilce koloni adı verilen yapıya örnektir.
Mikroorganizmalar = Mikroplar - Bakteriler, Mayalar, Küfler, Algler, Protozoa gözle görülmez; çok küçüktür. - Virüsler ayrı bir gruptur, çok küçüktür. - Şapkalı Mantarlar, Yosunlar, Likenler gözle görülebilir. - Koloni gözle görülebilir. Koloni milyarlarca mikroorganizmanın yaptığı özel bir topluluktur. Ekmek ve limondaki küf, reçeldeki maya, sirke anası, iltihaplı sivilce koloni adı verilen yapıya örnektir.
 MİKROORGANİZMALARIN YARARLARI - Gıda Üretimi (yoğurt, boza, alkollü içecekler vb. ) - Endüstriyel Ürünlerin Üretimi (alkol, aseton vb. ) - Biyolojik Atık Su Arıtımı - Biyogaz Üretimi - Maden Yataklarının Islahı - Biyolojik Gübre Üretimi - Tarımsal Savaş İlaçları (Biyoinsektisit) Üretimi - Doğada C, N, P, S Döngüleri - Genetik Çalışmalar
MİKROORGANİZMALARIN YARARLARI - Gıda Üretimi (yoğurt, boza, alkollü içecekler vb. ) - Endüstriyel Ürünlerin Üretimi (alkol, aseton vb. ) - Biyolojik Atık Su Arıtımı - Biyogaz Üretimi - Maden Yataklarının Islahı - Biyolojik Gübre Üretimi - Tarımsal Savaş İlaçları (Biyoinsektisit) Üretimi - Doğada C, N, P, S Döngüleri - Genetik Çalışmalar
 MİKROORGANİZMALARIN ZARARLARI -Ekonomik kayıplara neden olurlar. -İnsanları, hayvanları, bitkileri hastalandırır ve onları ÖLDÜRÜR. Gıda kaynaklı mikrobiyel hastalıklar 2 türdür: -Enfeksiyon: Hastalık, canlı bakterinin vücuda alınması ile oluşur. Bakteri zehrini bağırsakta oluşturur. Bulaşıcıdır. Salmonella, Listeria, Campylobacter, Yersinia, Vibrio, coli O 157: H 7, DEC vb. E. -İntoksikasyon: Zehir, gıda üzerinde oluşturulmuştur. Bulaşıcı İntoksikasyon değildir. Cl. botulinum, Staph. aureus, mikotoksinler (aflatoksin).
MİKROORGANİZMALARIN ZARARLARI -Ekonomik kayıplara neden olurlar. -İnsanları, hayvanları, bitkileri hastalandırır ve onları ÖLDÜRÜR. Gıda kaynaklı mikrobiyel hastalıklar 2 türdür: -Enfeksiyon: Hastalık, canlı bakterinin vücuda alınması ile oluşur. Bakteri zehrini bağırsakta oluşturur. Bulaşıcıdır. Salmonella, Listeria, Campylobacter, Yersinia, Vibrio, coli O 157: H 7, DEC vb. E. -İntoksikasyon: Zehir, gıda üzerinde oluşturulmuştur. Bulaşıcı İntoksikasyon değildir. Cl. botulinum, Staph. aureus, mikotoksinler (aflatoksin).
 ABD Hastalık Kontrol Merkezi Verileri GIDA KAYNAKLI OLMAK ÜZERE; 76 Milyon kişi/ yıl hastalanma 325. 000 kişi/ yıl hastaneye yatma 5. 000 kişi/ yıl ÖLÜM
ABD Hastalık Kontrol Merkezi Verileri GIDA KAYNAKLI OLMAK ÜZERE; 76 Milyon kişi/ yıl hastalanma 325. 000 kişi/ yıl hastaneye yatma 5. 000 kişi/ yıl ÖLÜM
 Meyve-Sebze kaynaklı bakteriyel salgınlar: 1988 -1998 (ABD) ; 57 salgın B. cereus: 1 Shigella: 3 Campylobacter: 2 ET E. coli: 2 E. coli 11: H 43 : 1 Salmonella 26 E. coli O 157: H 7 22
Meyve-Sebze kaynaklı bakteriyel salgınlar: 1988 -1998 (ABD) ; 57 salgın B. cereus: 1 Shigella: 3 Campylobacter: 2 ET E. coli: 2 E. coli 11: H 43 : 1 Salmonella 26 E. coli O 157: H 7 22
 Salmonella & Yumurta ABD ‘de 65 milyar/ yıl yumurta üretiliyor. Bunların %1 ‘inin Salmonella içerdiği saptanmış (S. enteritidis). 10, 2 milyon yumurta Salmonella ile tüketime sunuluyor. Yıkamanın riski artırdığı gösterilmiş. 2, 4 milyon kişi/ yıl hastalanıyor 660 bin kişi/ yıl tedavi görüyor 390 yıl/ kişi ölüyor
Salmonella & Yumurta ABD ‘de 65 milyar/ yıl yumurta üretiliyor. Bunların %1 ‘inin Salmonella içerdiği saptanmış (S. enteritidis). 10, 2 milyon yumurta Salmonella ile tüketime sunuluyor. Yıkamanın riski artırdığı gösterilmiş. 2, 4 milyon kişi/ yıl hastalanıyor 660 bin kişi/ yıl tedavi görüyor 390 yıl/ kişi ölüyor
 YA KUŞ GRİBİ ? ? ? Bitti mi? Abartılmış mıydı?
YA KUŞ GRİBİ ? ? ? Bitti mi? Abartılmış mıydı?
 Gıdalardaki 5 Önemli Risk Yetersiz Personel Hijyeni Yetersiz Pişirme Yetersiz Soğutma Kontamine Ekipman Kontamine Hammadde
Gıdalardaki 5 Önemli Risk Yetersiz Personel Hijyeni Yetersiz Pişirme Yetersiz Soğutma Kontamine Ekipman Kontamine Hammadde
 w w w. m i k r o b i y o l o j i. o r g
w w w. m i k r o b i y o l o j i. o r g
 Mikroorganizmalar Üzerine Etki Eden Faktörler Besin Maddeleri, Sıcaklık, Su, Asitlik, Oksijen. Bir mikroorganizmayı; Geliştirmek, Gelişmeyi Yavaşlatmak, Gelişmeyi Durdurmak Öldürmek FARKLIDIR.
Mikroorganizmalar Üzerine Etki Eden Faktörler Besin Maddeleri, Sıcaklık, Su, Asitlik, Oksijen. Bir mikroorganizmayı; Geliştirmek, Gelişmeyi Yavaşlatmak, Gelişmeyi Durdurmak Öldürmek FARKLIDIR.
 Mikroorganizma Gelişme Hızı İkiye bölünerek çoğalırlar. Optimum koşullarda 8 dakikada bir bölünen bakteriler vardır. E. coli için bu süre 15 dakikadır. Buna göre 1 adet E. coli 15 dakika sonra 2, 30 dakika sonra 4, 45 dakika sonra 8, …. 3 saat sonra 4096, … 5 saat sonra 1. 048. 576, … 6 saat sonra 16, 8 milyon sayıya erişir. 7. saatte sayı 268, 4 milyondur.
Mikroorganizma Gelişme Hızı İkiye bölünerek çoğalırlar. Optimum koşullarda 8 dakikada bir bölünen bakteriler vardır. E. coli için bu süre 15 dakikadır. Buna göre 1 adet E. coli 15 dakika sonra 2, 30 dakika sonra 4, 45 dakika sonra 8, …. 3 saat sonra 4096, … 5 saat sonra 1. 048. 576, … 6 saat sonra 16, 8 milyon sayıya erişir. 7. saatte sayı 268, 4 milyondur.
 Gelişmenin Yavaşlatılması Mikroorganizma gelişmesi (2 ‘ye bölünmesi); Soğutma, Isıtma, Asitlendirme, Kurutma vb. şekillerde yavaşlatılabilir. E. coli ‘de 2 ‘ye bölünme süresi; 15 dakika ise 6, 5 saatte, 30 dakika ise 13 saatte, 60 dakika ise 26 saatte 108 sayıya erişir.
Gelişmenin Yavaşlatılması Mikroorganizma gelişmesi (2 ‘ye bölünmesi); Soğutma, Isıtma, Asitlendirme, Kurutma vb. şekillerde yavaşlatılabilir. E. coli ‘de 2 ‘ye bölünme süresi; 15 dakika ise 6, 5 saatte, 30 dakika ise 13 saatte, 60 dakika ise 26 saatte 108 sayıya erişir.
 Mikroorganizma Başlangıç Sayısı E. coli ‘nin ikiye bölünme süresi 30 dakika ise 108 sayıya çıkması için geçen süre: 1 bakteride 435 dakika (7 saat 15 dakika), 10 bakteride 390 dakika (6 saat 30 dakika), 100 bakteride 330 dakika (5 saat 30 dakika), 1. 000 bakteride 285 dakika (4 saat 45 dakika), 10. 000 bakteride 240 dakika (4 saat), 100. 000 bakteride 180 dakika (3 saat) gerekir. Üründe bakteri sayısının 0 olması çok zordur ama olabildiğince az sayıda olması da bozulmayı geciktirir.
Mikroorganizma Başlangıç Sayısı E. coli ‘nin ikiye bölünme süresi 30 dakika ise 108 sayıya çıkması için geçen süre: 1 bakteride 435 dakika (7 saat 15 dakika), 10 bakteride 390 dakika (6 saat 30 dakika), 100 bakteride 330 dakika (5 saat 30 dakika), 1. 000 bakteride 285 dakika (4 saat 45 dakika), 10. 000 bakteride 240 dakika (4 saat), 100. 000 bakteride 180 dakika (3 saat) gerekir. Üründe bakteri sayısının 0 olması çok zordur ama olabildiğince az sayıda olması da bozulmayı geciktirir.
 TÜM CANLILARIN SICAKLIK İSTEKLERİ 8 -10 o. C 25 -30 o. C 55 -60 o. C -Soğuk sevenler : . . A------İ------Ü. . . . . -Ilık sevenler : . . A------İ------Ü. . . . . -Sıcak sevenler : . . A------İ------Ü. . Tüm canlıların türlere göre değişen sıcaklık istekleri vardır. Buzdolabı ve dondurma sıcaklığı mikroplar için öldürücü değildir. Kaynatma kısmen öldürücüdür. Sporlu bakteriler canlı kalır. Otoklav (düdüklü tencere) sıcaklığı tümüyle öldürücüdür. Gıdalar 5 -65 o. C dışında tutulurlarsa BOZULMAZLAR
TÜM CANLILARIN SICAKLIK İSTEKLERİ 8 -10 o. C 25 -30 o. C 55 -60 o. C -Soğuk sevenler : . . A------İ------Ü. . . . . -Ilık sevenler : . . A------İ------Ü. . . . . -Sıcak sevenler : . . A------İ------Ü. . Tüm canlıların türlere göre değişen sıcaklık istekleri vardır. Buzdolabı ve dondurma sıcaklığı mikroplar için öldürücü değildir. Kaynatma kısmen öldürücüdür. Sporlu bakteriler canlı kalır. Otoklav (düdüklü tencere) sıcaklığı tümüyle öldürücüdür. Gıdalar 5 -65 o. C dışında tutulurlarsa BOZULMAZLAR
 GIDANIN NEMİ -Kuru meyveler, süttozu mikroorganizma gelişmesi açısından dayanıklıdırlar. Yaş meyveler ve süt ise aynı açıdan kurularına göre daha dayanıksızdır. -Gıdanın kurutulması soğutma gibi etki gösterir. Kurutulmuş gıdada mikroorganizmalar ölmez, sadece gelişmeleri durur. Gıda tekrar su aldığında gelişme ve çoğalma devam eder. Depodaki nem önemlidir. Depo kuru olmalıdır.
GIDANIN NEMİ -Kuru meyveler, süttozu mikroorganizma gelişmesi açısından dayanıklıdırlar. Yaş meyveler ve süt ise aynı açıdan kurularına göre daha dayanıksızdır. -Gıdanın kurutulması soğutma gibi etki gösterir. Kurutulmuş gıdada mikroorganizmalar ölmez, sadece gelişmeleri durur. Gıda tekrar su aldığında gelişme ve çoğalma devam eder. Depodaki nem önemlidir. Depo kuru olmalıdır.
 Asitlik Yoğurt, Turşu, Sucuk, Meyve suları, Bazı peynirler, Salça, Reçeller “Yüksek Asitli” gıdalar sayılır ve bunlar düşük asitli olanlara göre daha geç bozulurlar. İçme sütü, Sebzeler, Salatalar, Sütlü tatlılar, Etler (kırmızı, beyaz, su ürünleri) düşük asitlidir.
Asitlik Yoğurt, Turşu, Sucuk, Meyve suları, Bazı peynirler, Salça, Reçeller “Yüksek Asitli” gıdalar sayılır ve bunlar düşük asitli olanlara göre daha geç bozulurlar. İçme sütü, Sebzeler, Salatalar, Sütlü tatlılar, Etler (kırmızı, beyaz, su ürünleri) düşük asitlidir.
 Oksijen Canlıların çoğu için oksijen gerekir. Tetanos mikrobu oksijende gelişemez. Koli basili her ikisinde de gelişir. Küfler oksijen olmadan gelişemez. Bu nedenle gıdalar vakumda korunur.
Oksijen Canlıların çoğu için oksijen gerekir. Tetanos mikrobu oksijende gelişemez. Koli basili her ikisinde de gelişir. Küfler oksijen olmadan gelişemez. Bu nedenle gıdalar vakumda korunur.
 Koruyucu Maddeler Bazı gıdalarda (salam, sosis, mayonez, ketçap, balık ezmesi vb. ) yasal olarak koruyucu madde bulunmasına izin verilir. Bu gibi gıdalarda normal raf ömrü içinde ve depolama koşullarına uyulursa mikrobiyel bozulma görülmez.
Koruyucu Maddeler Bazı gıdalarda (salam, sosis, mayonez, ketçap, balık ezmesi vb. ) yasal olarak koruyucu madde bulunmasına izin verilir. Bu gibi gıdalarda normal raf ömrü içinde ve depolama koşullarına uyulursa mikrobiyel bozulma görülmez.
 BULAŞMA KAYNAKLARI - Hammadde - Yardımcı Maddeler - Ambalaj Materyali - İşletme Koşulları - Sinekler, Kemirgenler, Kuşlar - İşletme Havası - İşletmede Kullanılan Su - Ziyaretçiler - ÇALIŞANLAR
BULAŞMA KAYNAKLARI - Hammadde - Yardımcı Maddeler - Ambalaj Materyali - İşletme Koşulları - Sinekler, Kemirgenler, Kuşlar - İşletme Havası - İşletmede Kullanılan Su - Ziyaretçiler - ÇALIŞANLAR
 Çapraz Bulaşma Tüketime Hazır Gıdanın Kontaminasyonudur Çiğ gıda, füme balık, Çalışanlar (el, giysi), Kesme tahtası, bıçak vs. , Temizlik malzemesi, Damlayan, sıçrayan su, Kirli kaplar, Çöp toplama
Çapraz Bulaşma Tüketime Hazır Gıdanın Kontaminasyonudur Çiğ gıda, füme balık, Çalışanlar (el, giysi), Kesme tahtası, bıçak vs. , Temizlik malzemesi, Damlayan, sıçrayan su, Kirli kaplar, Çöp toplama
 Çapraz Bulaşma Engellenebilir; Düzenli el yıkamak, Temiz ekipman kullanmak, Çiğ ve hazır gıdayı ayrı tutmak, Çalışma alanını temiz tutmak, Kişisel eşyaya dikkat etmek, Çöp uzaklaştırmaya dikkat etmek, Giyime dikkat etmek.
Çapraz Bulaşma Engellenebilir; Düzenli el yıkamak, Temiz ekipman kullanmak, Çiğ ve hazır gıdayı ayrı tutmak, Çalışma alanını temiz tutmak, Kişisel eşyaya dikkat etmek, Çöp uzaklaştırmaya dikkat etmek, Giyime dikkat etmek.
 El Yıkama Füme balık ve peynir gibi gıdalara, Çiğ salata, taze et, meyve ve sebzeye, Kirli her şey ellendiğinde el yıkanmalıdır. Tuvalet sonrası, yemek sonrası, Molalardan sonra el yıkanmalıdır. Dezenfektanlı sıvı sabun kullanılmalıdır. Tırnak temizliğine özen gösterilmelidir. Uygun el yıkama; Enfeksiyonları % 35 -50 azaltır, Gastrointestinal hastalıkları % 80 azaltır.
El Yıkama Füme balık ve peynir gibi gıdalara, Çiğ salata, taze et, meyve ve sebzeye, Kirli her şey ellendiğinde el yıkanmalıdır. Tuvalet sonrası, yemek sonrası, Molalardan sonra el yıkanmalıdır. Dezenfektanlı sıvı sabun kullanılmalıdır. Tırnak temizliğine özen gösterilmelidir. Uygun el yıkama; Enfeksiyonları % 35 -50 azaltır, Gastrointestinal hastalıkları % 80 azaltır.
 El, Ne Zaman Yıkanmalı? • • Vücudun her hangi bir yerine temas ettiğinde, Hapşırma, öksürmeden sonra, Çiğ gıdalar ile temastan sonra, Hazır gıdayı taşımadan önce, Ellerin kirli olduğundan şüphe edildiğinde, İşe başlamadan önce, İş bitiminde. Her gerekli olduğunda,
El, Ne Zaman Yıkanmalı? • • Vücudun her hangi bir yerine temas ettiğinde, Hapşırma, öksürmeden sonra, Çiğ gıdalar ile temastan sonra, Hazır gıdayı taşımadan önce, Ellerin kirli olduğundan şüphe edildiğinde, İşe başlamadan önce, İş bitiminde. Her gerekli olduğunda,
Etkin El Yıkama
Etkin El Yıkama
 -Açık üretim alanları ve kritik ürün üretiminde öksürüp hapşırırken: -Gıda maddelerinden uzak durun, -Bir defa kullanılıp atılan mendiller kullanın, -Mendili hemen çöpe atın ve -Ellerinizi yıkayıp dezenfekte etmeyi kesinlikle unutmayın !
-Açık üretim alanları ve kritik ürün üretiminde öksürüp hapşırırken: -Gıda maddelerinden uzak durun, -Bir defa kullanılıp atılan mendiller kullanın, -Mendili hemen çöpe atın ve -Ellerinizi yıkayıp dezenfekte etmeyi kesinlikle unutmayın !
 Kişisel Sağlık Önemlidir Elde kesik ve yara, Vücutta iltihap, İshal, Ateş, Yorgunluk, Burun ve geniz akıntısı, Hatta grip, nezle Olan kişiler gıdayla doğrudan temas etmemelidir Portör kontrolü çok önemlidir.
Kişisel Sağlık Önemlidir Elde kesik ve yara, Vücutta iltihap, İshal, Ateş, Yorgunluk, Burun ve geniz akıntısı, Hatta grip, nezle Olan kişiler gıdayla doğrudan temas etmemelidir Portör kontrolü çok önemlidir.
 Özellikle Hassas Ürünler ile Kritik Açık Çalışma Alanlarında Ağız maskesi, bone ve eldiven kullanılması zorunludur (? ? ? ) Peki yemek yerken. . . ? Ağız, burun ve saçlar kapatılmış olmalı, maske ve bone düzenli değiştirilmelidir. Eldivenler takılmadan önce eller yıkanıp dezenfekte edilmeli, kirlendiği, yırtıldığı veya çalışma yeri değiştirildiğinde mutlaka yenilenmelidir.
Özellikle Hassas Ürünler ile Kritik Açık Çalışma Alanlarında Ağız maskesi, bone ve eldiven kullanılması zorunludur (? ? ? ) Peki yemek yerken. . . ? Ağız, burun ve saçlar kapatılmış olmalı, maske ve bone düzenli değiştirilmelidir. Eldivenler takılmadan önce eller yıkanıp dezenfekte edilmeli, kirlendiği, yırtıldığı veya çalışma yeri değiştirildiğinde mutlaka yenilenmelidir.
 Normal hayatta yapmayacağınız bir şeyi gıda işletmesinde Hiç Yapamazsınız !
Normal hayatta yapmayacağınız bir şeyi gıda işletmesinde Hiç Yapamazsınız !
 Üretim sırasında mümkün olduğu kadar: İstediği kadar lezzetli olsun; denemek, tadına bakmak, hele parmaklamak kesinlikle OLMAZ!.
Üretim sırasında mümkün olduğu kadar: İstediği kadar lezzetli olsun; denemek, tadına bakmak, hele parmaklamak kesinlikle OLMAZ!.
 Mutfakta nerede bir kül tablası gördünüz ? İnşallah ! Çalışma alanında değil, Depoda değil, Üretim alanında hiç değil, Tuvaletlerde de değil ! Hiç içmeseniz çok daha iyi ama İlle de içecekseniz Sadece belirlenen yerlerde içebilirsiniz !
Mutfakta nerede bir kül tablası gördünüz ? İnşallah ! Çalışma alanında değil, Depoda değil, Üretim alanında hiç değil, Tuvaletlerde de değil ! Hiç içmeseniz çok daha iyi ama İlle de içecekseniz Sadece belirlenen yerlerde içebilirsiniz !
 Gıda Maddelerinin Ambalajlanması • Hava geçirmezlik ve sağlamlık☺ • Kir ve toza karşı korunmuşluk☺ • Bombajlı, şişmiş ambalajlar • Vakum eksikliği • Sıkı kapatılmamış kavanozlar • Sızıntı yapan teneke kutular • Salamurada atipik bulanıklık • Teneke kutuların paslanması • Gıda maddesinin küflenmesi • Derin dondurulmuş gıdaların Karlanması veya buzlanması • Depolardaki hijyenik koşullar ! • Nakliye hijyeni !
Gıda Maddelerinin Ambalajlanması • Hava geçirmezlik ve sağlamlık☺ • Kir ve toza karşı korunmuşluk☺ • Bombajlı, şişmiş ambalajlar • Vakum eksikliği • Sıkı kapatılmamış kavanozlar • Sızıntı yapan teneke kutular • Salamurada atipik bulanıklık • Teneke kutuların paslanması • Gıda maddesinin küflenmesi • Derin dondurulmuş gıdaların Karlanması veya buzlanması • Depolardaki hijyenik koşullar ! • Nakliye hijyeni !
 Soğuk Zincirdeki Kontrol Noktaları: • Soğutma derecelerinin ayarlanması • Sıcaklık kontrollerinin düzenli yapılması • Ölçü aletlerinin çalışıp, çalışmadığının kontrolü • Alet ve makinelerin bakımı, kalibrasyon • Soğutulmadan bekleme süresinden kaçınma • Aşırı yüklemeden kaçınma • Ambalajların kontrolü • Temsili örneklerin kontrolü • Soğutulmamış ürünler için önlem alınması
Soğuk Zincirdeki Kontrol Noktaları: • Soğutma derecelerinin ayarlanması • Sıcaklık kontrollerinin düzenli yapılması • Ölçü aletlerinin çalışıp, çalışmadığının kontrolü • Alet ve makinelerin bakımı, kalibrasyon • Soğutulmadan bekleme süresinden kaçınma • Aşırı yüklemeden kaçınma • Ambalajların kontrolü • Temsili örneklerin kontrolü • Soğutulmamış ürünler için önlem alınması
 Mutfak Hijyeni; c. GMP, GHP Çalışma alanındaki pislik ve genel düzensizlikten kaçınmak. Çöp ve ambalaj malzemelerini derhal uzaklaştırmak. Odalar, duvarlar, tavan, kapılar, pencereler, çalışma alanları, alet ve makinelerde hijyenik önlemler almak. Yeterli aydınlatma ve havalandırma sağlamak. Kişisel temizliğe özen göstermek. Fiziksel ve kimyasal kontaminasyondan kaçınmak. Kemirgenler, böcekler, sinekler, kuşlar vb. hayvanlara karşı önlem almak
Mutfak Hijyeni; c. GMP, GHP Çalışma alanındaki pislik ve genel düzensizlikten kaçınmak. Çöp ve ambalaj malzemelerini derhal uzaklaştırmak. Odalar, duvarlar, tavan, kapılar, pencereler, çalışma alanları, alet ve makinelerde hijyenik önlemler almak. Yeterli aydınlatma ve havalandırma sağlamak. Kişisel temizliğe özen göstermek. Fiziksel ve kimyasal kontaminasyondan kaçınmak. Kemirgenler, böcekler, sinekler, kuşlar vb. hayvanlara karşı önlem almak
 Makine ve Aletlerin Temizlik ve Dezenfeksiyonu Özellikle kritik gıda maddelerinin hazırlanması sırasında kirliliğin ve mikrop bulaşmasının önüne geçmek için gereklidir. Kritik Gıda Maddeleri: Et, balık, tavuk eti, yumurta, salatalar, süt ürünleri gibi kolaylıkla bozulabilen ürünlerdir. Buz çoğu kere ihmal edilir ancak, mikrop barındırır.
Makine ve Aletlerin Temizlik ve Dezenfeksiyonu Özellikle kritik gıda maddelerinin hazırlanması sırasında kirliliğin ve mikrop bulaşmasının önüne geçmek için gereklidir. Kritik Gıda Maddeleri: Et, balık, tavuk eti, yumurta, salatalar, süt ürünleri gibi kolaylıkla bozulabilen ürünlerdir. Buz çoğu kere ihmal edilir ancak, mikrop barındırır.
 Mutfakta Yerleşim Mutfakta tüketime hazır gıda ile hammadde ve/veya kirli malzeme karşılaşmamalıdır (çöp!!!). Buna göre işlem sırasına ve mutfak yerleşimine özen gösterilmelidir. Pozitif basınçlı temiz hava çoğu kontaminasyonu engeller. H a t a D o ğ r u
Mutfakta Yerleşim Mutfakta tüketime hazır gıda ile hammadde ve/veya kirli malzeme karşılaşmamalıdır (çöp!!!). Buna göre işlem sırasına ve mutfak yerleşimine özen gösterilmelidir. Pozitif basınçlı temiz hava çoğu kontaminasyonu engeller. H a t a D o ğ r u
 Depolar Hammadde deposu, hazırlanmış gıda deposu, lojistik depolar; Ayrı olmalıdır. Her türlü kontaminasyondan kaçınılmalıdır. Materyal ile duvar arasında makul bir boşluk olmalıdır. Depo aşırı doldurulmamalıdır. Nem, havalandırma, sıcaklık kontrolü sürekli izlenmelidir. Kalibrasyon önemlidir. İlk giren ilk çıkar (Fi. FO) kuralına uyulmalıdır. Depo düzeni buna göre olmalıdır.
Depolar Hammadde deposu, hazırlanmış gıda deposu, lojistik depolar; Ayrı olmalıdır. Her türlü kontaminasyondan kaçınılmalıdır. Materyal ile duvar arasında makul bir boşluk olmalıdır. Depo aşırı doldurulmamalıdır. Nem, havalandırma, sıcaklık kontrolü sürekli izlenmelidir. Kalibrasyon önemlidir. İlk giren ilk çıkar (Fi. FO) kuralına uyulmalıdır. Depo düzeni buna göre olmalıdır.
 Revizyon= Varolan Bir Sistemin Gözden Geçirilip Yeniden Sunulması Bir Revizyonun Nedenleri Aşağıdaki Gibidir: • Reçetenin Değiştirilmesi • Üretim Dizaynının Değiştirilmesi • Yeni Alınan Alet ve Makineler • Mevzuatın Değiştirilmesi • Müşteri ve Tedarikçi İlişkilerinin Değişmesi • Tekrar Eden Müşteri Şikayetleri • Yeni Bir Ürün Geliştirilmiş Olması • Ticari Alanda Yeni bir Sipariş Alınması • Müşteri Talepleri • Bölüm Spesifikasyonlarının Değişmesi Otokontrol Sisteminin Rutin Olarak Gözden Geçirilmesi ile Hata ve Eksiklikler Tanınıp Önlenebilecektir.
Revizyon= Varolan Bir Sistemin Gözden Geçirilip Yeniden Sunulması Bir Revizyonun Nedenleri Aşağıdaki Gibidir: • Reçetenin Değiştirilmesi • Üretim Dizaynının Değiştirilmesi • Yeni Alınan Alet ve Makineler • Mevzuatın Değiştirilmesi • Müşteri ve Tedarikçi İlişkilerinin Değişmesi • Tekrar Eden Müşteri Şikayetleri • Yeni Bir Ürün Geliştirilmiş Olması • Ticari Alanda Yeni bir Sipariş Alınması • Müşteri Talepleri • Bölüm Spesifikasyonlarının Değişmesi Otokontrol Sisteminin Rutin Olarak Gözden Geçirilmesi ile Hata ve Eksiklikler Tanınıp Önlenebilecektir.
 İşletme İçerisinde Alınacak Önlem ve Kontroller için Kesiksiz Hijyen Düzenlemeleri Gerekir. Bunlar: • Risk analizleriyle, • KKN‘lerin belirlenmesiyle, • Sınır değerlerin tespitiyle, • Düzeltici önlemlerle, • Şahit örneklerin incelenmesiyle, • Periyodik düzenlemeyle, • Çalışma kurallarına uyumla, • Sorumlulukların belirlenmesi ile, • Hijyen eğitimi ile, • Hataların açıkça bildirilmesiyle, • Yıllık revizyon ile Sağlanabilir.
İşletme İçerisinde Alınacak Önlem ve Kontroller için Kesiksiz Hijyen Düzenlemeleri Gerekir. Bunlar: • Risk analizleriyle, • KKN‘lerin belirlenmesiyle, • Sınır değerlerin tespitiyle, • Düzeltici önlemlerle, • Şahit örneklerin incelenmesiyle, • Periyodik düzenlemeyle, • Çalışma kurallarına uyumla, • Sorumlulukların belirlenmesi ile, • Hijyen eğitimi ile, • Hataların açıkça bildirilmesiyle, • Yıllık revizyon ile Sağlanabilir.
 HACCP İşletme için koruyucu hekimliktir. Hata oluşmasını önlemeye odaklanır. Her boydaki gıda işletmesine uygundur. Potansiyel tehlikeye karşı önceden önlem alır. Kritik kontrol noktaları ve kontrol noktaları vardır. İşletmeye özgüdür. Uygulanması yasal zorunluluktur. Müşteriye güven verir. Belge şart değildir.
HACCP İşletme için koruyucu hekimliktir. Hata oluşmasını önlemeye odaklanır. Her boydaki gıda işletmesine uygundur. Potansiyel tehlikeye karşı önceden önlem alır. Kritik kontrol noktaları ve kontrol noktaları vardır. İşletmeye özgüdür. Uygulanması yasal zorunluluktur. Müşteriye güven verir. Belge şart değildir.
 Mutfakta Gıda Güvenliği, Kontroller -Sıcaklık Kontrolü; Basit Termometre. -Süre Kontrolü; Basit bir Saat, Takvim. -Hijyen Kontrolü; Basit Aparatlar. -Kayıtlar; Basit Defter, Kalem. Başarısızlık % 87. 5 Ölçme: %10 Önleme % 2. 5
Mutfakta Gıda Güvenliği, Kontroller -Sıcaklık Kontrolü; Basit Termometre. -Süre Kontrolü; Basit bir Saat, Takvim. -Hijyen Kontrolü; Basit Aparatlar. -Kayıtlar; Basit Defter, Kalem. Başarısızlık % 87. 5 Ölçme: %10 Önleme % 2. 5
 KALİTE BİR BÜTÜNDÜR, EKİP İŞİDİR. Beraber Çalışmayı Gerektirir.
KALİTE BİR BÜTÜNDÜR, EKİP İŞİDİR. Beraber Çalışmayı Gerektirir.
 Analiz Maliyeti -Her analizin bir maliyeti vardır. -Maliyet sadece besiyeri gideri değildir. -Depremlerde önce ucuz binalar yıkılır. -Analiz maliyeti en az olmalıdır. -Düşük fiyat her zaman ucuz olan değildir. -Sahte negatif ve pozitif sonuçlardan kaçınılmalıdır. -Örnekleme sıklığına karar verilmelidir. BU DA, BİR EKİP İŞİDİR.
Analiz Maliyeti -Her analizin bir maliyeti vardır. -Maliyet sadece besiyeri gideri değildir. -Depremlerde önce ucuz binalar yıkılır. -Analiz maliyeti en az olmalıdır. -Düşük fiyat her zaman ucuz olan değildir. -Sahte negatif ve pozitif sonuçlardan kaçınılmalıdır. -Örnekleme sıklığına karar verilmelidir. BU DA, BİR EKİP İŞİDİR.
 Risk Grupları Çocuklar, Yaşlılar, Hastalar, Hamileler.
Risk Grupları Çocuklar, Yaşlılar, Hastalar, Hamileler.
 Hastalanma Kişiye göre değişir: -Genel sağlık (stres) durumu önemlidir. -Ne kadar yedi? -Yanında ne yedi ne içti?
Hastalanma Kişiye göre değişir: -Genel sağlık (stres) durumu önemlidir. -Ne kadar yedi? -Yanında ne yedi ne içti?
 Sevgiyle, halkman@tr. net www. mikrobiyoloji. org www. kimyaevi. org www. gidadernegi. org
Sevgiyle, halkman@tr. net www. mikrobiyoloji. org www. kimyaevi. org www. gidadernegi. org


